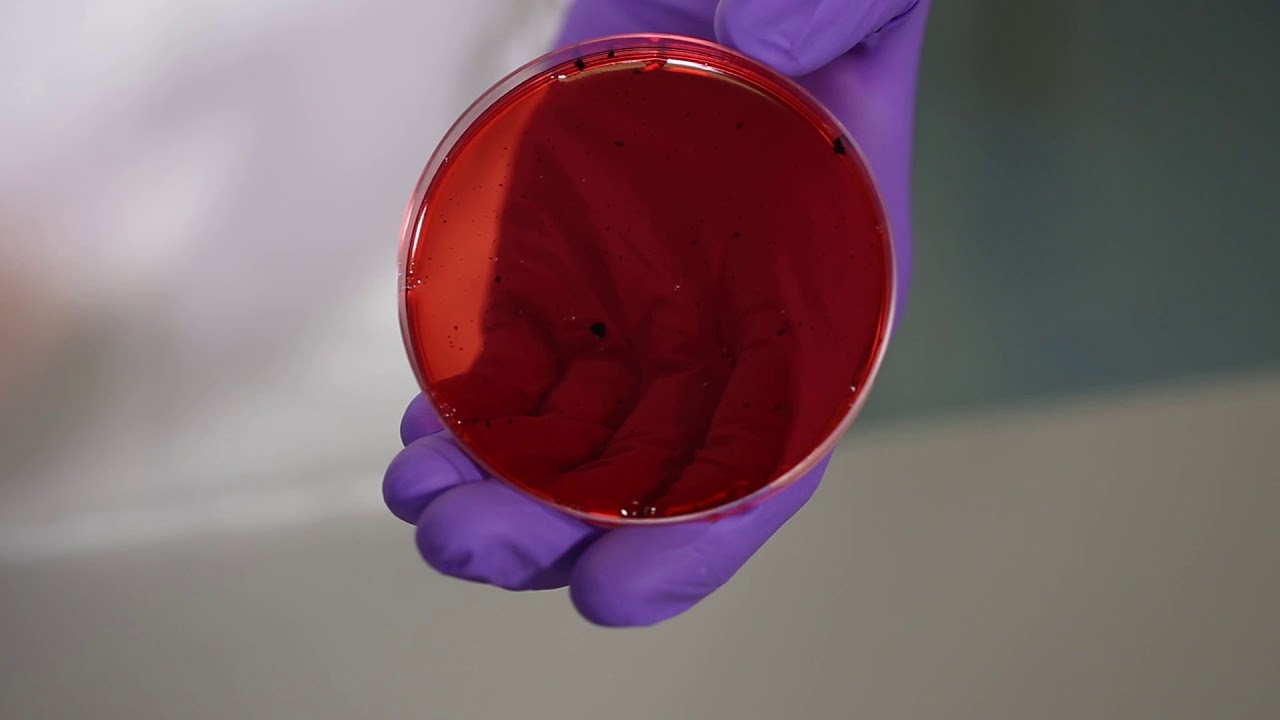
Mobirise

Dehydrated Culture Media
Our Dehydrated Culture Media used for the enrichment, isolation and identification of microorganisms. We import from renowned manufactures in Europe.
They use major raw material which come from different part of European countries. It is tested to the highest standards, performance, pH, solubility, and gel strength and bio burden. It has been formulated to dissolve quickly for increased solubility.
We offer excellent equivalency & homogeneity, outstanding value for dehydrated culture media. You can use our Dehydrated Culture Media products with complete confidence.





SHARE THIS PAGE!